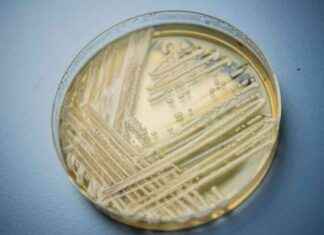
Experten warnen vor gefährlichen Pilz-Infektionen news-21092024-222529

Schlagwort: Gesundheitsrisiken
Ist Hafermilch gesund? Arzt überrascht mit Diagnose
Überraschenderweise empfahl mir mein Arzt, die Hafermilch aus meinem Speiseplan zu streichen. Ich war perplex. Wie konnte diese gesunde, pflanzliche Alternative, die ich so sehr liebte, plötzlich schädlich sein? Mein Arzt erklärte mir, dass...
Die Auswirkungen von Alkohol auf die Gesundheit: Was Sie wissen müssen
Die Auswirkungen von Alkohol auf die Gesundheit: Was Sie wissen müssen Berlinale-Filmkritik | "What Does That Nature Say to You" Am Donnerstag startete Hong Sangsoo zum achten Mal in den Berlinale-Wettbewerb und präsentierte seinen Film "What...
Rückkehr zu Masken: Infektiologe empfiehlt klare Maßnahmen für den Covid-Herbst
Die Covid-19-Risiko ist gesunken, aber die Fallzahlen steigen. Experten empfehlen klare Maßnahmen für den Herbst. Die Zahl der Fälle steigt wieder an, besonders betroffen ist Sachsen-Anhalt. Im Winter nehmen Erkältungen zu, da sich Viren...
Risiko im Nagelstudio: Krebs durch zwei Behandlungen
Berlin. Das Streben nach perfekt manikürten Nägeln kann ernsthafte Gesundheitsrisiken mit sich bringen. Neben den bekannten Gefahren von UV-Lacken und Kunst-Nägeln warnt eine Hautärztin vor weiteren potenziellen Gefahrenquellen. Die Verwendung von UV-Lacken und Gelbeschichtungen für...
Experten warnen vor gefährlichen Pilz-Infektionen
Berlin. In einer kürzlich veröffentlichten Warnung haben Experten vor gefährlichen Pilzinfektionen gewarnt, die tödlich sein können. Vier Arten von Pilzen geben Anlass zur Sorge, wobei eine davon sogar von Mensch zu Mensch übertragen werden...
Ursache und Auswirkungen des Großbrands in Reinickendorf – Rauch über Berlin
Ursache und Auswirkungen des Großbrands in Reinickendorf - Rauch über Berlin Ein verheerender Großbrand hat am Dienstagabend in Berlin-Reinickendorf nahe dem ehemaligen Flughafen Tegel für einen Großeinsatz der Feuerwehr gesorgt. Eine Lagerhalle in der Nähe...
Berlin Marathon: Laufen mit künstlichen Gelenken
Berlin Marathon: Laufen mit künstlichen Gelenken 82-jährige Lauf-Veteranen Mit künstlichen Gelenken zum Berliner Marathon-Jubiläum 1974 gewann der Postbote Günter Hallas den ersten Berlin-Marathon. Zum 50. Jubiläum wird der 82-Jährige dort ein letztes Mal an den Start gehen...
Verletzung von drei Personen durch brennenden Flüssiggastank
Verletzung von drei Personen durch brennenden Flüssiggastank Bei einem Brand eines Flüssiggastanks auf einem Grundstück im Potsdamer Ortsteil Groß Glienicke sind am Freitagabend drei Menschen verletzt worden. Eine Person erlitt schwere Brandverletzungen und musste per...